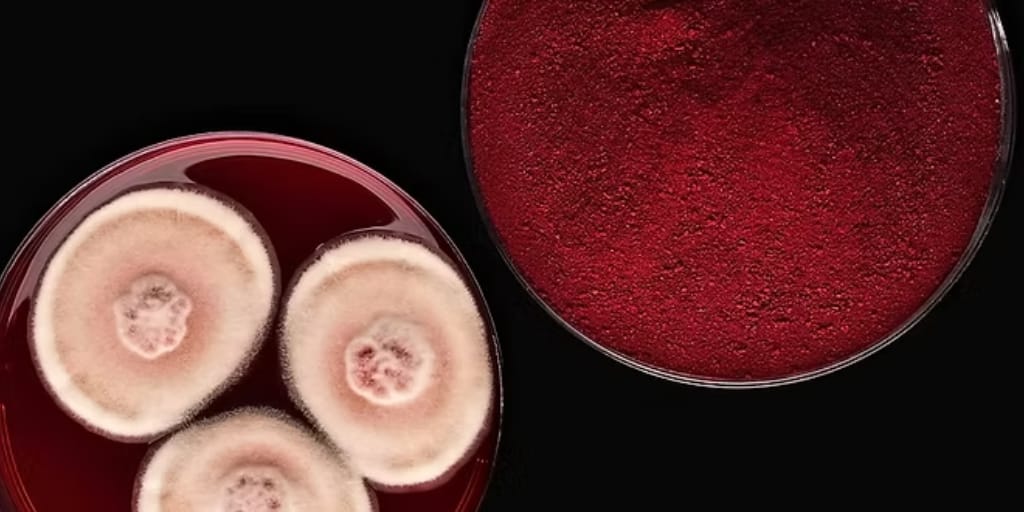

- ClimateHack Weekly
- Posts
- 🚢 Vol 159: Could Fusion Power Ships?
🚢 Vol 159: Could Fusion Power Ships?
Plus: 30 heating and cooling startups mapped. 40 Climate solutions US VCs are betting on next
Happy Thanksgiving to all those who celebrate 🎊
Here at Hack, our end of year celebrations take place at the HackSummit in New York (December 10-11th) where we’ll bring together the Climate Deep Tech community to fast forward fundraising activities before EOY. And we’d love to see you there.
It’s the perfect excuse to catch up with familiar faces, learn from rising stars across the ClimateTech ecosystem and find new investors with $60Bn of Climate Capital combined.
To make it easier to attend, use code SUMMITINSIDER for 40% off. Valid until December 1st. You’re welcome. 🎁
And as a little extra holiday cheer: one lucky attendee will receive a free pass to bring a plus-one, doubling the networking (and the fun).
In this week’s edition:
💰 Just Climate secured $375 million to scale natural climate solutions
🌱 Ponda raised +€2M to commercialise its regenerative plant-based insulation BioPuff.
🔥 Overstory closed $43 million to advance AI-powered wildfire risk and grid resilience technology
The Digest
❄️ The Heating and Cooling Tech Stack, mapped by Axeleo Capital.
💸 Exclusive: Discover the top 40 solutions US investors are looking to fund next with Collab Fund, M1C, Pangaea Ventures, Newlab, Shadow Ventures, VoLo Earth
📈 What’s up? Australia’s climate tech sector now encompasses 730+ startups employing over 7,000 people and attracting $680 million in venture funding in 2025, according to data from Climate Salad.
📉 What’s down? Battery recycling firm Redwood Materials has cut “dozens” of jobs as it pivots away from ambitious battery-recycling and cathode projects toward grid-scale energy storage and critical-minerals extraction amid weakening EV demand.
🍄 The Future is Fungi Award 2025 has named Michroma as the €250,000 first-place winner, with Mycolever and HIRO Technologies taking second and third place, recognising all three for pioneering fungal-based innovations in food ingredients, sustainable cosmetics and rapidly decomposable diapers.
AgriFood x Climate
Credit: Chromologics
🦗 nextProtein raised €18 million in a Series B round led by SWEN Capital Partners and British International Investment, enabling it to open a second facility in Tunisia and scale production of its insect-based protein ingredients to 12,000 tonnes per year.
❤️ Danish biotech Chromologics secured €7 million, in a funding round led by Novo Holdings, EIFO, Döhler Ventures, Collateral Good Ventures and Synergetic, to support regulatory approvals and scale production of its fermentation-derived natural red colour.
🍗 Israel’s SuperMeat secured $3.5 million, including a $2 million commitment from Agronomics, to accelerate the commercialisation of its cultivated chicken in Europe, following major progress in cost reduction and sustainability performance.
🏭 RespectFarms has launched the world’s first pilot farm for cultivated meat in the Netherlands, enabling dairy farmer Corné van Leeuwen to produce cell-based proteins with EU agricultural funding.
Biodiversity x Climate

Credit: Overstory
🔥 Overstory raised $43 million in a Series B funding round led by Blume Equity, with participation from Energy Impact Partners and existing investors, to advance its AI-powered wildfire risk and grid resilience technology.
🍄 Rhizocore Technologies secured £4.5million in a funding round led by The First Thirty to scale production of its RhizoPellet™ mycorrhizal fungal technology, which is designed to significantly improve tree survival and growth, and to support expansion into the North American reforestation market.
🦇 Video: New bat NatureTech converts raw video into clean flight paths, roost counts and behavioural insights, without the usual black-box constraints. See how it works.
Chemistry x Climate

Credit: VectorMine/Shutterstock
🧪 Researchers at UNIST have developed a low-voltage electrochemical system that converts CO₂ into formic acid with ~75% less energy and triple the production rate of current methods, thanks to a stable copper-silver catalyst and a more efficient oxidation reaction.
💡 Opinion: Chemistry wasn't Northvolt's problem. Manufacturing was. And why there won’t be a single winner.
🔦 Who You’ll Meet at the HackSummit Startup Fair
Spanning 6 verticals, meet 23 promising ClimateTechs from across NYC, the US and around the world will showcase at the HackSummit in New York next month.
Their Founders and CEOs come to the HackSummit eager to demo their groundbreaking technologies and are actively seeking their next big collaboration, investment, or partnership to scale their impact.
Get ready to meet the teams behind advancements in zero-carbon power from Ammonia, advancements in nuclear fusion, chemical recycling using hydrogen, efficient magnesium production and turning mining waste into next‑gen construction materials to name a few.
Energy x Climate

Credit: X-energy
⚡️ X-energy closed its Series D funding round with $700 million. The round was led by Jane Street with participation from Ares Management funds, ARK Invest, Corner Capital, Emerson Collective, Galvanize, Hood River Capital Management, NGP, Point72, Reaves Asset Management, Segra Capital Management and XTX Ventures, and it will use the funds to build out the supply chain for its small modular nuclear reactors.
📶 Tallinn-based PowerUP Energy Technologies raised €10 million in a Series A funding round co-led by Mercaton and ScaleWolf, with participation from SmartCap Green Fund. It will use the funds to scale manufacturing and commercial deployment of its hydrogen fuel cell generators for dual-use civilian and defence applications.
🛳️ Maritime Fusion raised $4.5 million in a seed funding round led by Trucks VC, with Aera VC, Alumni Ventures, Paul Graham, Y Combinator and others participating, to develop a ship-based tokamak fusion reactor, aiming to bring clean maritime power online in the early 2030s.
🏘️ Installio, a London-based clean energy and heat pump technology firm, secured £1.5 million seed funding in a round led by Verb Ventures to support its national rollout and enable high-quality, scalable retrofit installations across the UK.
☄️ The Trump administration has overhauled the US Department of Energy, eliminating several clean energy offices while creating a new Office of Fusion and consolidating fossil and geothermal functions, shifting emphasis from renewables toward fusion commercialisation.
☀️ Elon Musk’s xAI plans to build an 88-acre solar farm supplying a small share of power to its massive Memphis Colossus data center, amid controversy over the facility’s unpermitted gas turbines and resulting air pollution in nearby communities.
💡 What 41 AI startups tell us about pricing for the energy transition and the physical world.
Has Clean Energy Met its Match with Crux?
Since joining us at last year’s HackSummit, Crux closed its Series B, bringing the total venture capital raised to over $77 million, and expanded the team to more than 70 people.
Now Crux’s ambitions go far beyond growth, to redefine how energy project financing works in the United States. And Co-Founder and CEO Alfred Johnson joined Josh Dorfman of Supercool to share how an AI-enabled software layer can unlock the hardware and physical layer that deep decarbonization demands.
Next up, Co-Founder and CEO Alfred Johnson sits down with Marc Andrusko of Andreessen Horowitz at the HackSummit to share his pathway to make energy project financing more liquid, efficient, and intelligent, unlocking the capital needed to power America’s clean energy future.
Funds x Climate

Credit: Future Energy Ventures
⚡️ Future Energy Ventures closed its €205 million Fund II, alongside a €30 million Italy-focused vehicle, backed by investors including E.ON, EIF, KFW Capital and ABN AMRO, to scale digital and asset-light technologies driving the global energy transition.
💰 Just Climate secured $375 million from global institutional investors to scale natural climate solutions, with its first investments including Indian agritech platform AgroStar to drive climate-resilient, sustainable land use.
🛞 EIT Urban Mobility committed up to €44 million over the next three years to continue investing in scalable, socially beneficial urban mobility innovations across Europe.
Materials x Climate

Credit: Ponda
🌱 UK startup Ponda raised €2.09 million seed funding, in a round co-led by Faber and Counteract, with participation from PDS Ventures, Evenlode Impact and the Royal College of Art, to commercialise its regenerative plant-based insulation BioPuff.
Methane x Climate

Credit: Ruminant BioTech
🐄 Ruminant BioTech, based in New Zealand, secured $9.5 million in a Series A funding round co-led by Rosrain Investments and Cultivate Ventures with support from Marex and AgriZeroNZ. It will use the funds to commercialise its long-acting methane-reducing bolus for pasture-based cattle ahead of a 2026 launch.
Mobility x Climate

Credit: Matrix Charging Interest Group
🚖 The Matrix Charging Interest Group, founded by Audi, Easelink, Nissan and Voyah, launched an industry initiative to standardise Easelink’s automated conductive EV charging technology, enabling global interoperability and broad market adoption.
🚘 Berlin-based NexDash raised €5 million in a seed funding round led by Extantia Capital and Clean Energy Ventures to build its AI-driven “Neo-Carrier” model, designed to electrify and consolidate Europe’s road freight sector through a Trucking-as-a-Service platform.
Water x Climate

💦 The UK is launching a £25 million Water Efficiency Lab competition, offering up to £1.5 million per project in its first year to fund innovations that help consumers and businesses better understand and reduce their water use.
Optics x Action x Climate
Mind the gap between looking green and being green.
We’d love to hear from you, how did you like today's email?


